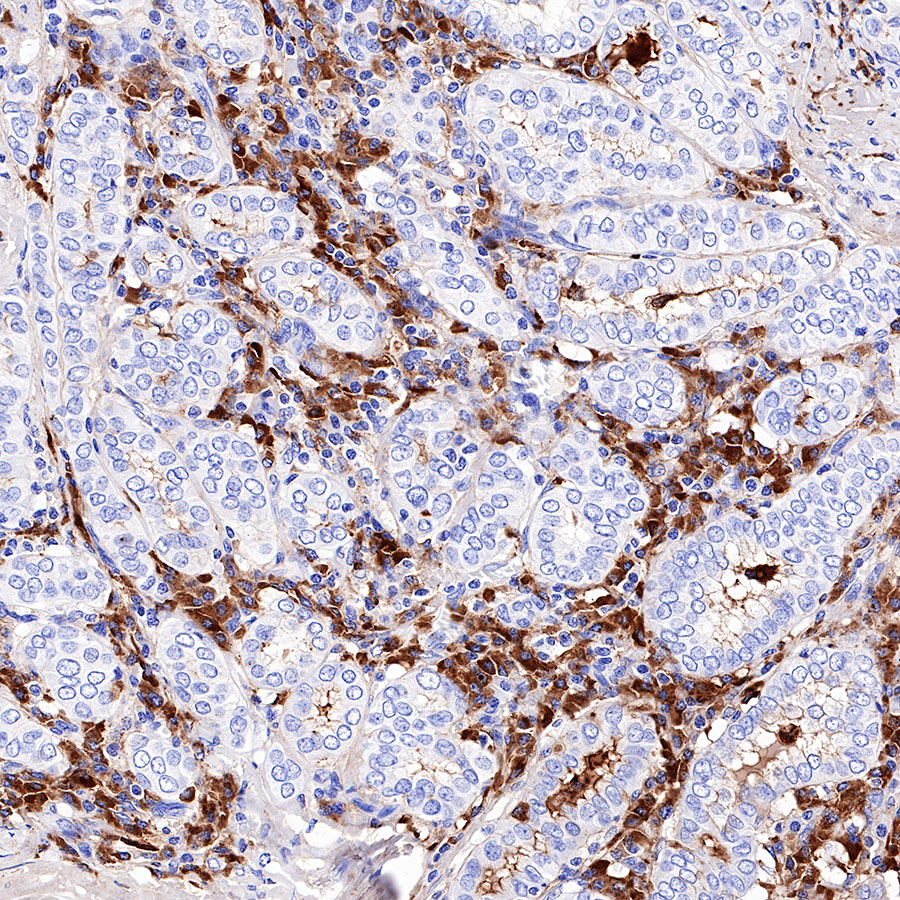
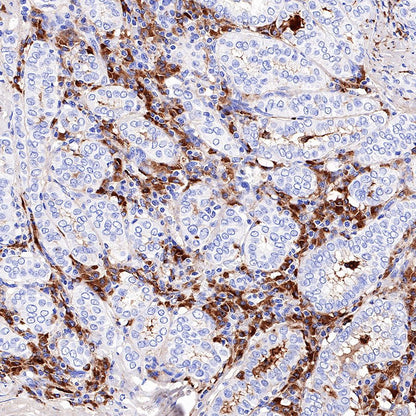

Product Details
Product Details
Product Specification
| Host | Rabbit |
| Antigen | Kappa light chain |
| Synonyms | N/A |
| Immunogen | N/A |
| Clone Number | SDT-R130 |
| Antibody Type | Recombinant mAb |
| Application | WB, IHC-P |
| Reactivity | Hu |
| Purification | Protein A |
| Concentration | 0.5 mg/ml |
| Physical Appearance | Liquid |
| Storage Buffer | PBS, 40% Glycerol, 0.05% BSA, 0.03% Proclin 300 |
| Stability & Storage | 12 months from date of receipt / reconstitution, -20 °C as supplied |
Dilution
| application | dilution | species |
| WB | 1:1000 | null |
| IHC-P | 1:500 | null |
Background
There are two types of light chains: kappa and lambda chains. The ratio or proportion between the kappa and lambda light chains indicates an excess production of one chain over the other, and therefore can be used as an indication of disease progression or remission.
Picture
Picture
Western Blot

WB result of Kappa light chain Rabbit mAb Primary antibody: Kappa light chain Rabbit mAb at 1/1000 dilution Lane 1: Human serum lysate 20 µg Secondary antibody: Goat Anti-Rabbit IgG, (H+L), HRP conjugated at 1/10000 dilution Predicted MW: 12kDa Observed MW: 24kDa
Immunohistochemistry

IHC shows positive staining in paraffin-embedded human tonsil. Anti-Kappa light chain antibody was used at 1/500 dilution, followed by a HRP Polymer for Mouse & Rabbit IgG (ready to use). Counterstained with hematoxylin. Heat mediated antigen retrieval with Tris/EDTA buffer pH9.0 was performed before commencing with IHC staining protocol.

IHC shows positive staining in paraffin-embedded human spleen. Anti-Kappa light chain antibody was used at 1/500 dilution, followed by a HRP Polymer for Mouse & Rabbit IgG (ready to use). Counterstained with hematoxylin. Heat mediated antigen retrieval with Tris/EDTA buffer pH9.0 was performed before commencing with IHC staining protocol.

IHC shows positive staining in paraffin-embedded human colon. Anti-Kappa light chain antibody was used at 1/500 dilution, followed by a HRP Polymer for Mouse & Rabbit IgG (ready to use). Counterstained with hematoxylin. Heat mediated antigen retrieval with Tris/EDTA buffer pH9.0 was performed before commencing with IHC staining protocol.

IHC shows positive staining in paraffin-embedded human cervical squamous cell carcinoma. Anti-Kappa light chain antibody was used at 1/500 dilution, followed by a HRP Polymer for Mouse & Rabbit IgG (ready to use). Counterstained with hematoxylin. Heat mediated antigen retrieval with Tris/EDTA buffer pH9.0 was performed before commencing with IHC staining protocol.
IHC shows positive staining in paraffin-embedded human thyroid cancer. Anti-Kappa light chain antibody was used at 1/500 dilution, followed by a HRP Polymer for Mouse & Rabbit IgG (ready to use). Counterstained with hematoxylin. Heat mediated antigen retrieval with Tris/EDTA buffer pH9.0 was performed before commencing with IHC staining protocol.